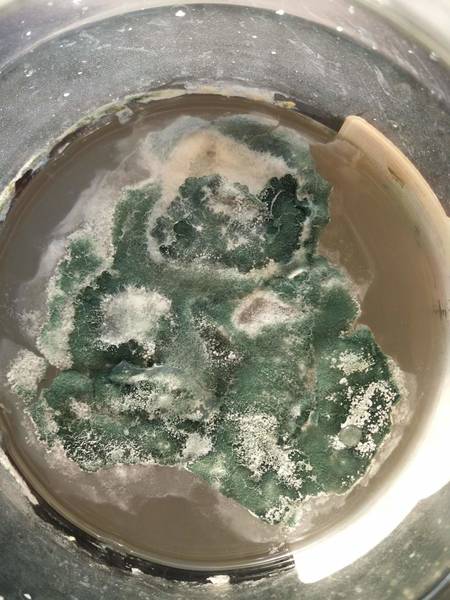

Триходерма на трутовиках: уникальные снимки

Раздел: Мир вокруг нас